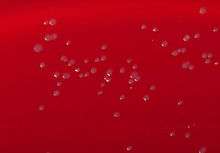

Corynebacterium renale
| Corynebacterium renale | |
|---|---|
![]() | |
| Blood agar plate culture of Corynebacterium renale | |
| Scientific classification | |
| Kingdom: | Bacteria |
| Phylum: | Actinobacteria |
| Order: | Actinomycetales |
| Family: | Corynebacteriaceae |
| Genus: | Corynebacterium |
| Species: | C. renale |
| Binomial name | |
| Corynebacterium renale (Migula, 1900) Ernst, 1906 | |
Corynebacterium renale is a pathogenic bacterium that causes cystitis and pyelonephritis in cattle.[1]
C. renale is a facultatively anaerobic Gram-positive organism, characterized by nonencapsulated, nonsporulated, immobile, straight or curved rods with a length of 1 to 8 µm and width of 0.3 to 0.8 µm, which forms ramified aggregations in culture (looking like "Chinese characters").
The bacterium is sensitive to the majority of antibiotics, such as the penicillins, ampicillin, cephalosporins, quinolones, chloramphenicol, tetracyclines, cefuroxime, and trimethoprim.
References
- ↑ "Bovine Cystitis and Pyelonephritis". The Merck Veterinary Manual. 2006. Retrieved 2007-06-05.
Further reading
- Srivastava, Preeti (16 November 2010). "Physiological and biochemical consequences of host-plasmid interaction - A case study with Corynebacterium renale, a multiple cryptic plasmid containing strain". Plasmid. 65 (2): 110–117.
External links
This article is issued from Wikipedia - version of the 10/8/2016. The text is available under the Creative Commons Attribution/Share Alike but additional terms may apply for the media files.